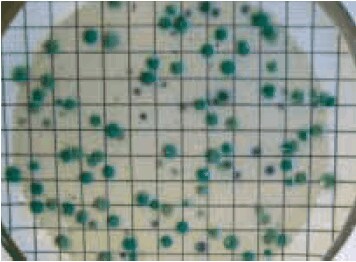
Figure 2 CP ChromoSelect Agar (C. perfringens appears as green colonies)

Clostridium perfringens, their Properties and their Detection
Clostridia are relatively large, Gram-positive, rod-shaped bacteria that can undergo only anaerobic metabolism. Most Clostridia cannot grow under aerobic conditions and can even be killed by exposure to O2; however, they form endospores that are able to survive long periods of exposure to air and other adverse environmental conditions. The natural sources of clostridia are anaerobic habitats with organic nutrients, particularly soils, aquatic sediments, and the intestinal tracts of animals. Their fermentation of organic compounds, such as sugars, produces large amounts of CO2 and H2 as well as volatile organic compounds like acetic and butyric acid, acetone, and butanol. Metabolism of substrates like amino acids and fatty acids results in foul-smelling degradation products. Clostridia also have an extended range of extracellular enzymes that degrade large biological molecules in the environment into fermentable compounds. Although there are non-pathogenic clostridia, this genus produces some of the most potent biological toxins. The three particularly lethal members of this group areC. perfringens, which is responsible for cooked meat-associated food poisoning and wound and surgical infections that lead to gas gangrene, C. tetani, which is responsible for deadly tetanus infections, and C. botulinum, which causes botulism.
Clostridium perfringens is found in undercooked or improperly sterillized canned foods (germination of endospores) and in water (surface water). The natural contamination source is human and animal feces mainly transmitted into food by water. C. perfringens produces an extensive range of invasins and exotoxins. The enterotoxins cause the undesirable, mostly meat-associated, food poisoning and wound and surgical infections that lead to gas gangrene.
C. perfringens plays a subsidiary role in water examination4. Clostridia are spore builders and are resistant to heating, chlorination and other stress factors. In contrast to vegetative cells like coliforms (E. coli, enterococci), which are less resistant, C. perfringens has the advantage of surviving longer6. Therefore, while a fecal contamination is detected mostly by coliforms as an indicator, which could disappear after a processing step, C. perfringens remains present. The organism is not a hazard in water; rather, it is problematic when the water comes in contact with food.
In consideration of the aforementioned facts, it is obvious that detection and identification of C. perfringens is an important step towards the control and eradication of this potent pathogen. Some characteristic enzymes of C. perfringens are hemolysins (ß-hemolysis), lecithinase, extracellular proteases, lipases (phospholipase-C), collagenase, hyaluronidase, saccharolytic enzymes and enzymes to reduce sulphite to sulphide. These enzymes are also used as detection and differentiation targets. It is also notable that C. perfringens is a non-motile bacterium and it is the most important of the sulphite-reducing clostridia. Also, C. perfringens normally grows at 44 °C, whereas some other clostridia are inhibited at this temperature. This property is used in ISO methods to give the medium more selectivity4.
For detection of C. perfringens, mCP and TSC agar have been recommended4, 5. However, there are problems associated with each of these media. The mCP method is very onerous for routine screening and bacterial colonies cannot be used for further biochemical testing. In addition, the recovery of C. perfringens was rejected by ISO in favor of methods based on TSC agar6. TSC detects all sulphite-reducing clostridia, however, and not only C. perfringens; in some cases, exces-sive blackening of the agar frustrated counting of the lower dilutions. On the other hand, if the contamination was too high, TSC did not consistently produce black colonies and, as a consequence, the colonies’ white color provided false negative results.
To prevent this problem, Sigma-Aldrich has introduced a new medium called CP ChromoSelect Agar, a chromogenic media from the new generation. Studies have shown that this medium produces counts that are not significantly different from those obtained from other media. The identification of typical and atypical colonies isolated from all media has demonstrated that CP ChromoSelect Agar (see Figure 1) was more specific to C. perfringens in water samples than mCP (see Figure 2) and TSCF agar.

Figure 1. Scanning electron micrograph of C. perfringens grown on a silicon wafer (source: S. Melville, Department of Biological Sciences, Virginia Tech University)
Figure 2.CP ChromoSelect Agar (C. perfringens appears as green colonies)
To keep Clostridium perfringens under control, Sigma-Aldrich has developed a broad range of selective media (Table 1), tests (Tables 2 and 3) and anaerobic equipment (Table 4) for the detection, identification and differentiation of clostridia.
Materials
References
To continue reading please sign in or create an account.
Don't Have An Account?